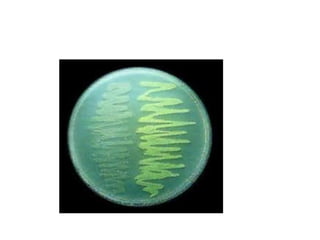
fisiologia bacteriana
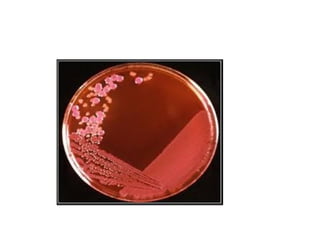
fisiologia bacteriana

El documento describe la fisiología bacteriana. Explica que el metabolismo bacteriano se divide en catabolismo y anabolismo. El catabolismo incluye la digestión, absorción y oxidación de nutrientes para liberar energía, mientras que el anabolismo usa esta energía para sintetizar componentes celulares. También describe los requerimientos nutricionales de las bacterias como fuentes de carbono, energía, micronutrientes y factores de crecimiento, así como las condiciones físico-químicas óptimas como pH, temper